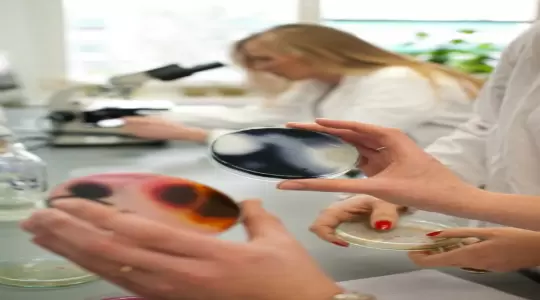
SGGW wśród najlepszych uczelni świata

SGGW wśród najlepszych uczelni świata
Szkoła Główna Gospodarstwa Wiejskiego otrzymała wyjątkowe wyróżnienie- dostała się do pierwszej setki najlepszych uczelni prowadzących studia w dziedzinie rolnictwa i leśnictwa.
SGGW to nowoczesny uniwersytet przyrodniczy oferujący studentom profesjonalne zaplecze do praktyki, nowoczesny kampus oraz współpracę z uczelniami na całym świecie. Uniwersytet od lat zajmuje wysokie miejsce w rankingach wyższych uczelni o profilu rolniczo-przyrodniczym.QS World University Rankings serwisu TopUniversities.com to już piąta edycja rankingu. Oprócz analizy ponad 17 milionów prac badawczych, ranking bierze pod uwagę także opinie ponad 85 tysięcy naukowców oraz 41 tysięcy pracodawców. W zestawieniu znajduje się aż 36 dyscyplin naukowych- to największa lista tego typu na świecie.Oprócz SGGW w rankingu znalazły się także inne polskie uczelnie- między innymi Uniwersytet Warszawski (150 pozycja) w kategoriach polityka i stosunki międzynarodowe, współczesne języki, matematyka i lingwistyka. UJ został wyróżniony za współczesne języki, zaś Politechnika Warszawska w kategorii inżynieria elektryczna i elektroniczna. Polskie uczelnie w ostatnim czasie wykazały duży wzrost konkurencyjności na arenie międzynarodowej.
Data publikacji: 25-03-2016
